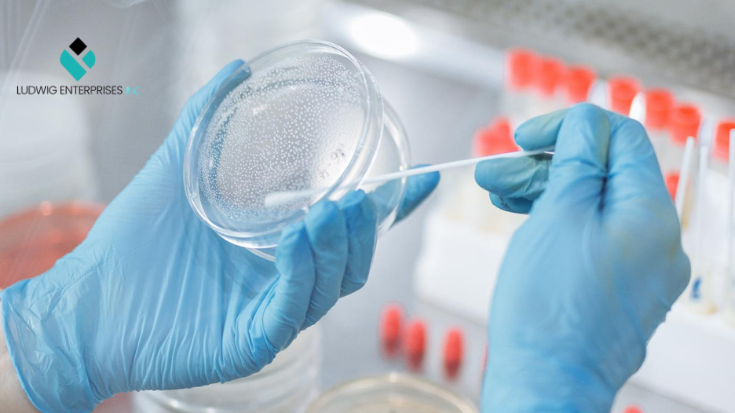
🧫 Cheek cells are rich in mRNA. Non-invasive doesn’t mean low-quality—it means smart.
🛠️ How it works:
🔹Cheek swab
🔹Amplify mRNA
🔹Next-gen sequencing
🔹AI classification
Simple for the patient. Powerful behind the scenes.
$LUDG – Ludwig Enterprises, Inc
Visit

Ludwig Enterprises Inc. | OTC:LUDG
@ludg_inc
Leader in mRNA Technology with the development of personalized therapeutics targeting illnesses such as cancer, diabetes, and heart disease. $LUDG
ID: 1544756843184291840
http://www.ludwigent.com 06-07-2022 18:55:19
155 Tweet
184 Followers
419 Following